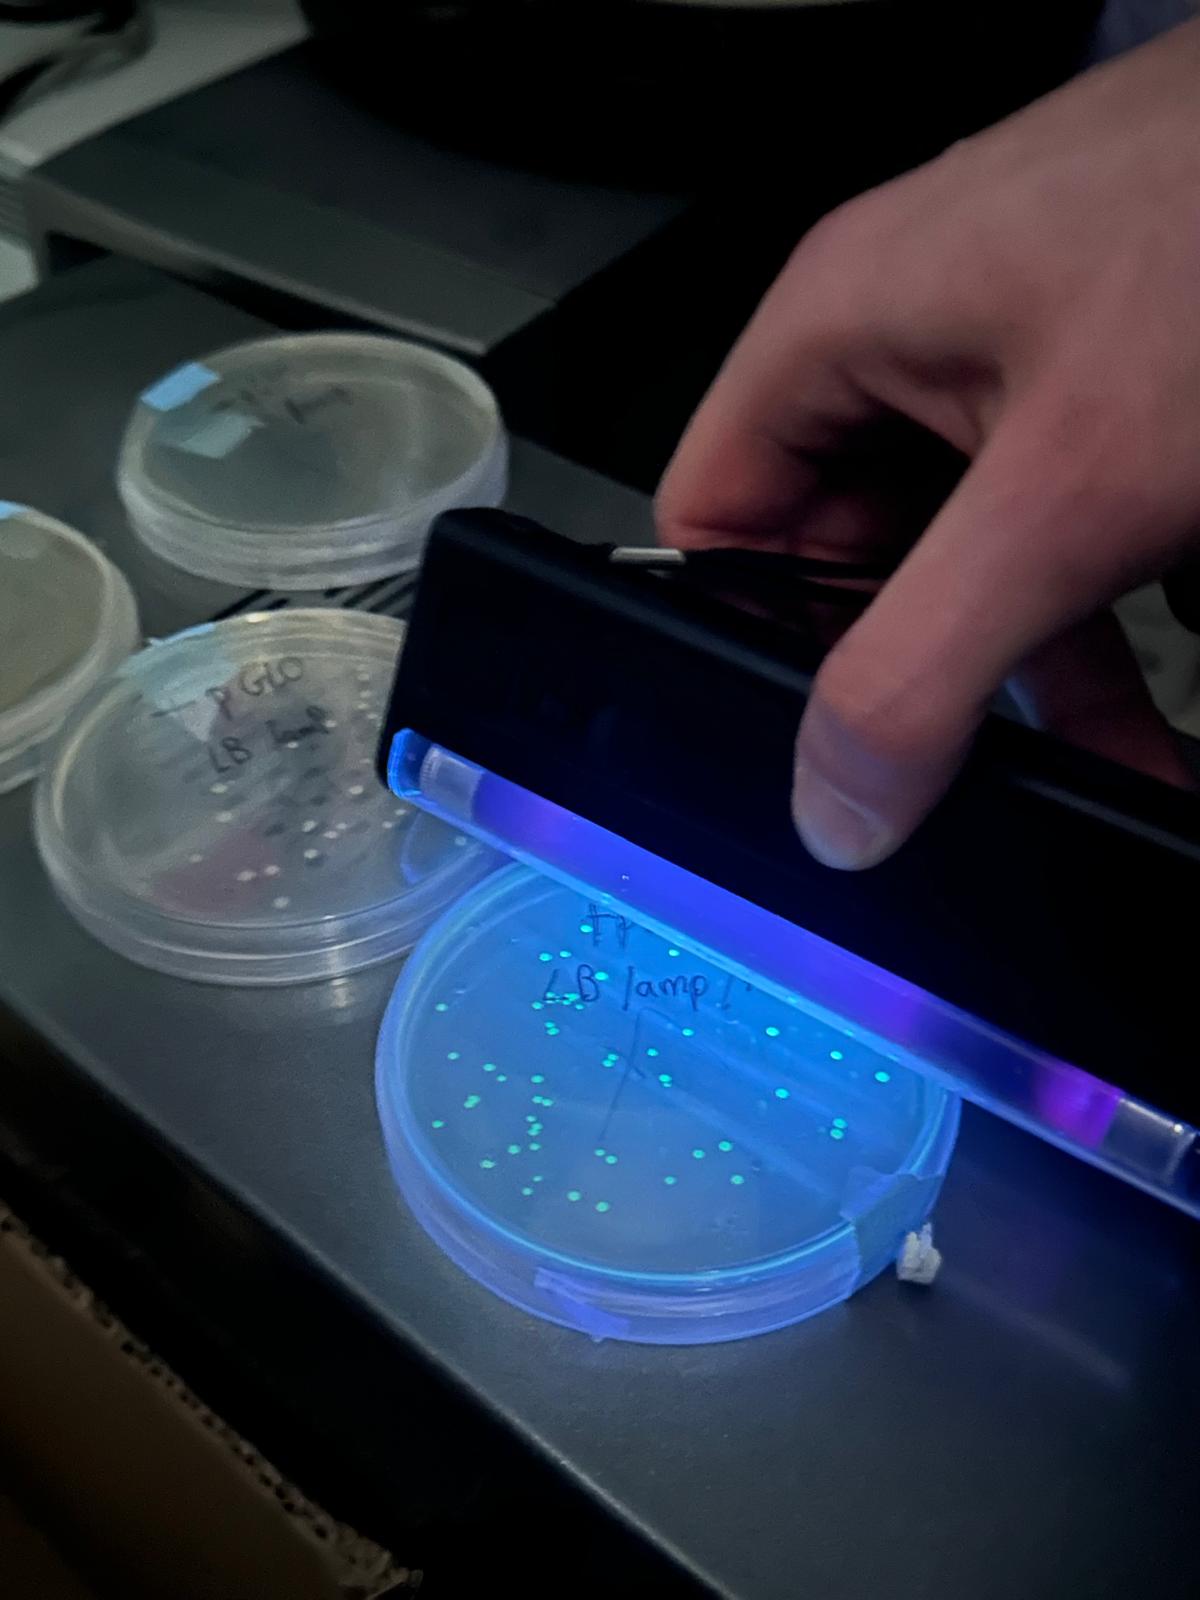

l’investigador Pau Sarlé de @ibbuab va fer una classe magistral sobre les claus de la genètica i la biotecnologia🧬 a l’alumnat que cursa l’optativa de Biologia i Geologia de 4t d’ESO, dins del programa #AmgenTransferCiència.
Mitjançant tècniques d’enginyeria genètica🧪van poder resoldre un cas de CSI👩🏽🔬
Estem molt contents d’haver pogut participar en aquest programa i de compartir la passió per la ciència al nostre alumnat!🤗
@fundaciorecerca